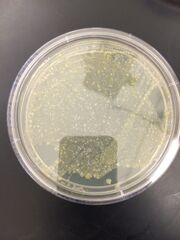
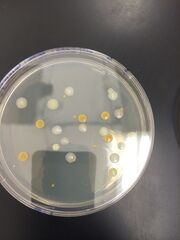

Uploads by Michael Robert Eckhart
From OpenWetWare
Jump to navigationJump to search
This special page shows all uploaded files.
| Date | Name | Thumbnail | Size | Description |
|---|---|---|---|---|
| 16:24, 18 February 2015 | Photo 5 (1).JPG (file) |  |
17 KB | |
| 16:24, 18 February 2015 | Photo 4 (1).JPG (file) |  |
17 KB | |
| 16:24, 18 February 2015 | Photo 3 (1).JPG (file) |  |
17 KB | |
| 16:21, 18 February 2015 | Photo 2 (1).JPG (file) |  |
19 KB | |
| 16:19, 18 February 2015 | Photo 1 (1).JPG (file) |  |
20 KB | |
| 15:41, 11 February 2015 | Photo 5 me.JPG (file) |  |
29 KB | |
| 15:40, 11 February 2015 | Photo 4 me.JPG (file) |  |
51 KB | |
| 15:40, 11 February 2015 | Photo 3 me.JPG (file) |  |
55 KB | |
| 15:39, 11 February 2015 | Photo 2 me.JPG (file) |  |
41 KB | |
| 15:39, 11 February 2015 | Photo 1 me.JPG (file) |  |
39 KB | |
| 01:29, 4 February 2015 | Michael final.JPG (file) |  |
1.38 MB | |
| 01:27, 4 February 2015 | Michael 16.JPG (file) |  |
1.45 MB | |
| 01:26, 4 February 2015 | Michael 15.JPG (file) |  |
1.43 MB | |
| 01:25, 4 February 2015 | Michael 14.JPG (file) |  |
1.53 MB | |
| 01:24, 4 February 2015 | Michael 13.JPG (file) | |
1.6 MB | |
| 01:22, 4 February 2015 | Michael 12.JPG (file) |  |
1.33 MB | |
| 01:22, 4 February 2015 | Michael 11.JPG (file) |  |
1.35 MB | |
| 01:21, 4 February 2015 | Michael 10.JPG (file) | |
1.27 MB | |
| 01:20, 4 February 2015 | Michael 9.JPG (file) |  |
1.41 MB | |
| 01:19, 4 February 2015 | Michael 8.JPG (file) |  |
1.56 MB | |
| 01:18, 4 February 2015 | Michael 7.JPG (file) |  |
1.44 MB | |
| 01:17, 4 February 2015 | Michael 6.JPG (file) |  |
1.57 MB | |
| 01:16, 4 February 2015 | Michael 5.JPG (file) |  |
1.44 MB | |
| 01:15, 4 February 2015 | Michael 4.JPG (file) |  |
1.44 MB | |
| 01:13, 4 February 2015 | Michael3.JPG (file) |  |
1.19 MB | |
| 01:11, 4 February 2015 | Michael2.JPG (file) |  |
1.64 MB | |
| 01:10, 4 February 2015 | Michael1.JPG (file) |  |
1.55 MB | |
| 02:46, 27 January 2015 | 1st lab m.jpg (file) |  |
1.34 MB | |
| 02:44, 27 January 2015 | 1st lab.JPG (file) |  |
1.34 MB |